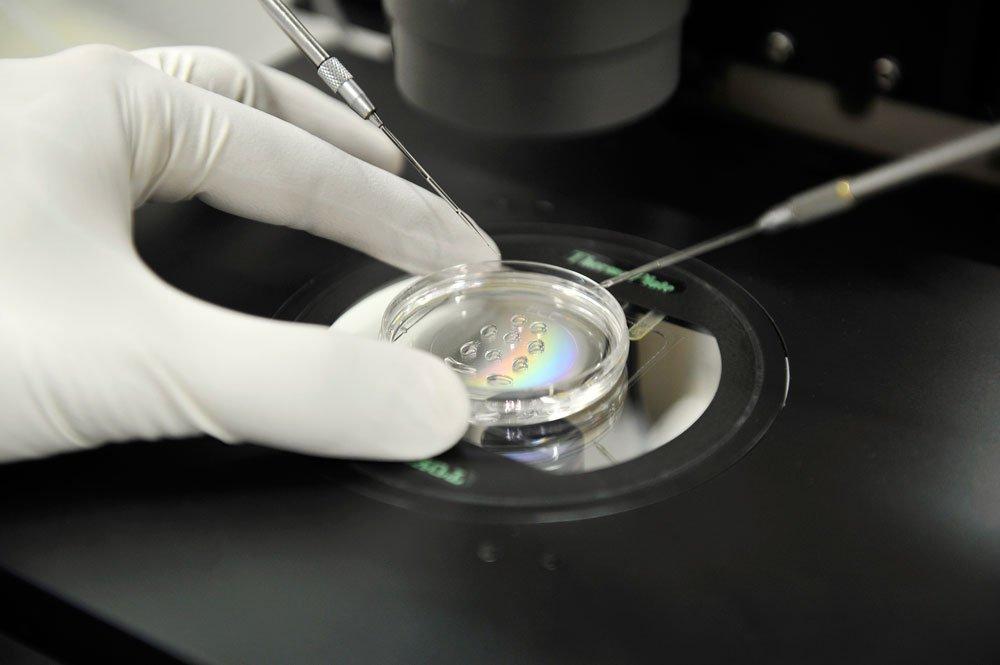
Tüp bebek yönteminde sperm kalitesi büyük önem taşıyor

Normal yollarla bebek sahibi olamayan çiftlerin tercih ettiği tüp bebek yönteminde başarı oranını yükselten bazı faktörler bulunmaktadır. Günümüzde oldukça yaygın kullanılan tüp bebek tedavisi işlemi için kullanılan spermin ve rahime yerleştirilen embriyonun kalitesi, başarılı bir gebelik için önemli bir parametre olarak ortaya çıkıyor. Medicana Bahçelievler Hastanesi Tüp Bebek Uzmanı Prof. Dr. Yavuz Aydın, tüp bebek tedavisi hakkında açıklamalarda bulunurken, sperm ve embriyo kalitesine dikkat çekti.

TÜP BEBEK İŞLEMİ
Tüp bebek tedavisi hakkında bilgiler veren Prof. Dr. Yavuz Aydın, “Tüp bebek işlemi, normal yollarla başarılı bir gebelik sonucuna ulaşamayan çiftlerde başvurduğumuz bir yöntem. Bu yöntemde kadının yumurtalıklarından olgunlaşmış yumurtaların toplanması ve erkekten de sperm alınması gerekiyor.” dedi.
Kadınlarda yumurta toplama işleminden önce yapılan prosedürlere de değinen Prof. Dr. Aydın, “Çeşitli prosedürler uygulayarak yumurtalıkların uyarılmasını ve istediğimiz miktarda yumurta üretmesini sağlıyoruz. Yumurta toplama için uygun zaman dilimi geldiğinde ise ultrason eşliğinde vajinadan yumurta toplama işlemini gerçekleştiriyoruz. Vajinal bölgeden yumurta toplama işlemi gerçekleştirilemiyorsa karından abdominalultrason eşliğinde yumurta toplama işlemi de yapılabiliyor. Toplanan yumurtaları besi ortamına aktarıyoruz ve bir sonraki işleme kadar sağlıklı kalmalarını sağlıyoruz.” diye konuştu.
Prof. Dr. Aydın, sperm alınması işlemi ile ilgili olarak da, “Tüp bebek işlemi için erkekten de sperm alınması gerekiyor. Genellikle erkek mastürbasyon yoluyla ejakülat oluşturuyor ve ejakülattaki sıvılardan spermler ayrılarak işleme hazır hale getiriliyor. Bazı durumlarda erkekten sperm almak için testise bir iğneyle girerek dokudan aspirasyon yapmak gerekebiliyor. Bu şekilde elde edilen spermi döllenme için kullanabiliyoruz. Elde edilen yumurta ve spermler farklı yöntemlerle döllenebiliyor. Fertilizasyonun, döllenmenin gerçekleşmesi için yumurta ve spermleri bir kapta karıştırarak belirli bir saat boyunca inkübe ediyoruz. ICSI (intrasitoplazmik Sperm İnjeksiyonu) olarak adlandırılan bir diğer yöntemle ise tek bir spermi olgun bir yumurtaya enjekte ederek döllenmeyi gerçekleştirebiliyoruz.” şeklinde konuştu.

“TRANSFER İÇİN EN SAĞLIKLI EMBRİYOLAR SEÇİLİYOR”
Prof. Dr. Aydın, döllenmeden sonra embriyolojik çalışmaların başladığının altını çizdi. Prof. Dr. Aydın sözlerine şöyle devam etti: “Döllenme sonucu oluşan yapıya zigot adı verilir. Daha sonra bu zigot hücre bölünmeleri ile embriyo halini alır. Embriyo, zamanla gelişerek bebeği oluşturuyor. Embriyonun sağlıklı olması, ilerleyen dönemde başarılı gebelik şansını oldukça etkileyen bir durum. Bu nedenle embriyoloji, anne rahmine transfer edilecek embriyonun sağlıklı olması ile ilgili çalışmalar yapıyor. Tüp bebekte başarı şansını artırmak için birden fazla yumurta döllenerek birkaç tane embriyo elde ediyoruz. Bu embriyolar anne rahmine nakledilmeden önce bir süre laboratuvar ortamında gelişiyor ve biz de bu süreçte embriyoları gözlem altında tutuyoruz.”
Embriyo transferi ile ilgili bilgi veren Prof. Dr. Aydın, “Nakil sırasında en sağlıklı embriyoların kullanılmasını hedefliyoruz. Bu nedenle laboratuvardaki embriyoları, döllenmeden itibaren belirli aralıklarla değerlendirmeye tabi tutuyoruz. Embriyodaki hücre sayısı, hücrelerin görünümleri gibi parametreleri değerlendirerek en sağlıklı embriyoyu belirlemeye çalışıyoruz. Daha sonra annenin yaşına bağlı olarak, en sağlıklı bir ya da iki embriyoyu rahme transfer ediyoruz.” açıklamasında bulundu.
SPERM KALİTESİNİN ÖNEMİ
Embriyo kalitesini etkileyen faktörlerden biri olan yumurta kalitesinin pek çok kişi tarafından bilindiğini ancak sperm kalitesi konusundaki farkındalığın daha az olduğunu ifade eden Prof. Dr. Aydın, “Sperm kalitesi, embriyo kalitesini etkileyen en önemli faktörlerden birisi. Sperm kalitesi dediğimiz zaman ejakülattaki sperm sayısı, hareketliliği ve şeklini kast ediyoruz. Normal yollarla döllenmenin gerçekleşebilmesi için tüm bu özelliklerin optimal düzeyde olması gerekiyor. Ancak bazı hormonal bozukluklar, testis hastalıkları gibi durumlarda ve özellikle 50 yaş üzeri erkeklerde sperm kalitesinde düşüş gözlemliyoruz. Ancak sperm kalitesinde düşüklük olması bebek sahibi olmaya engel değil. Spermin testisten aspirasyonla alındığı ve döllenmenin ICSI yöntemiyle gerçekleştirildiği tüp bebek işlemi, sperm kalitesi düşük erkeklerin de bebek sahibi olmasına yardımcı olabilir.” dedi.
Prof. Dr. Aydın, sözlerini şöyle tamamladı: “Sağlıklı beslenmek, ideal kiloda olmak, düzenli egzersiz yapmak pek çok konuda olduğu gibi sperm sağlığı üzerinde de olumlu etkiye sahip. Cinsel yolla bulaşan hastalıklardan korunmak da sperm sağlığını korumaya yardımcı oluyor. Sigara kullanan erkeklerin de sigarayı bırakması sperm sağlığını açısından büyük önem taşıyor.”